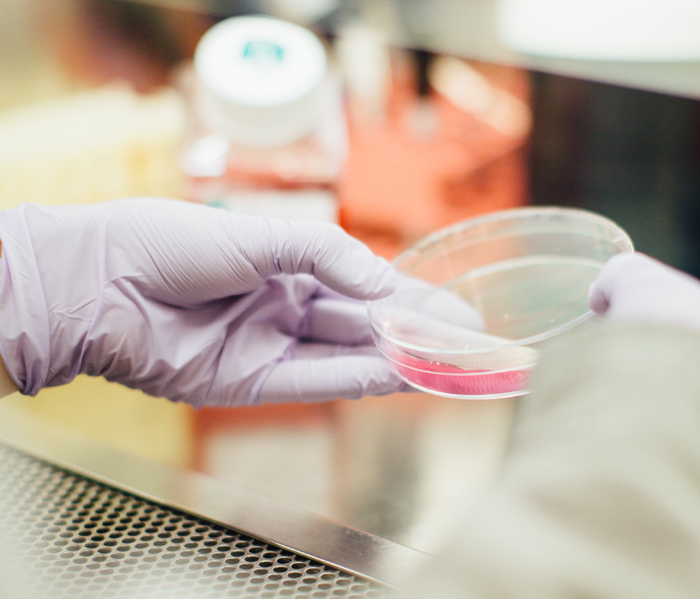

По мнению экспертов, новая мутация коронавируса может представлять «глобальную угрозу»
Все больше беспокойства у мирового
научного сообщества вызывает новая линия штаммов
Молекулярный биолог Константин Семенов рассказал изданию, что линия Лямбда «может представлять глобальную угрозу», так как имеет 8 ключевых мутаций, что, вероятно, делает его устойчивым к нейтрализующим антителам, которые были получены после вакцинации или после естественной инфекции
«Лямбда-вариант имеет высокую инфекционную способность, но больше всего беспокоит то, что он распространяется и в Чили, в которой вакцинировано около 60% населения. Однако в Чили 93% всех вакцинированных вакцинировано китайской вакциной КоронаВак, остальные Пфайзером. Под 60% понимается первая доза, а после первой дозы эффективность КоронаВака составляет 3%. То есть люди расслабились после первой дозы, отбросили все ограничения», — рассказала «Московскому комсомольцу» микробиолог, ассистент кафедры науки педагогического факультета Manchester Metropolitan University Виктория Доронина.
«Насколько вариант Лямбда опасен для России? Высокоинфекционные варианты стали появляться в Латинской Америке уже год назад. Но из-за сокращения авиасообщений они не получили распространения в Европе, включая Россию. Для России гораздо большую опасность представляет вариант Дельта (индийский). И опыт Британии показывает, что вакцинация ДНК-вакциной значительно сокращает число заболевших и тяжесть течения заболевания. В России такая вакцина есть», — считает эксперт.
В научном центре «Вектор» Роспотребнадзора вероятность того, что Лямбда сможет вытеснить Дельту, назвали «сомнительной». По данным Роспотребнадзора, в России пока случаи Лямбды не выявлены.
Комментарии